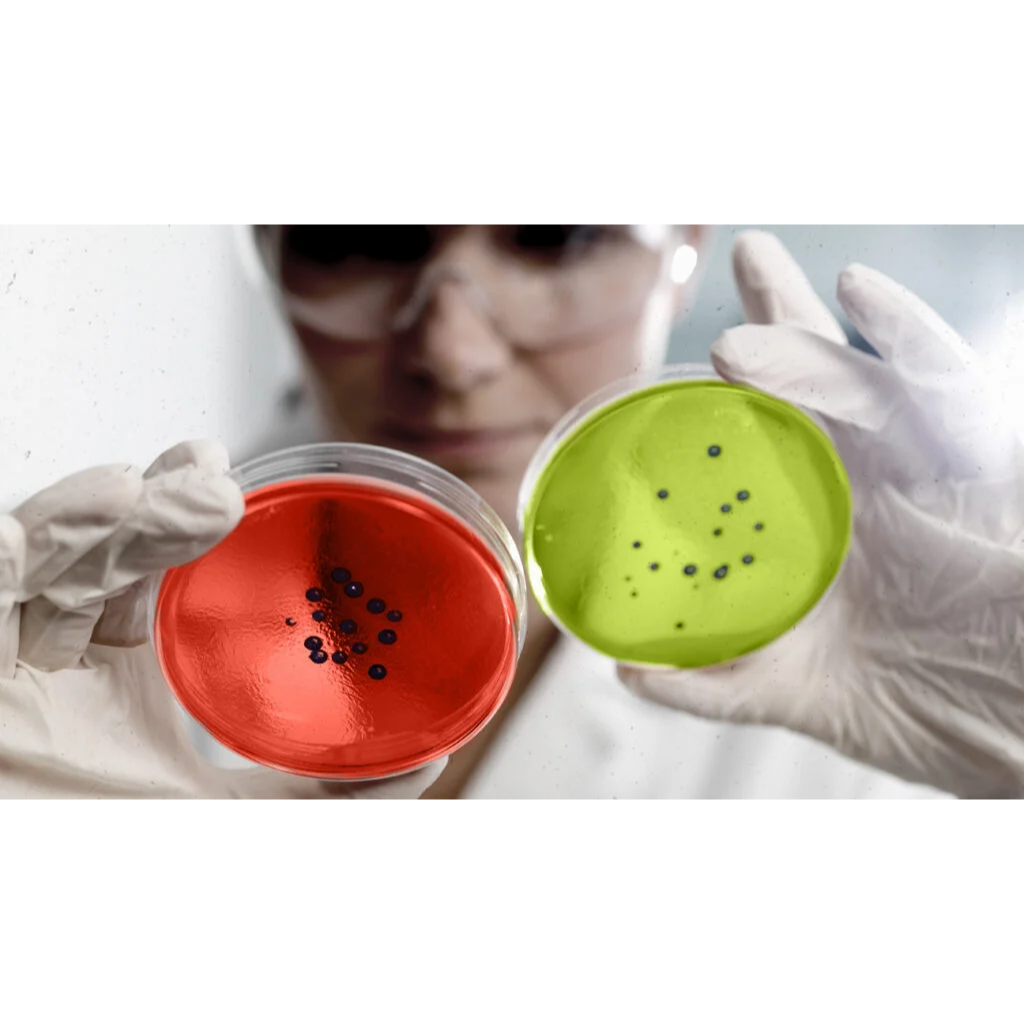
circleImg

Virtual Lab: Exploring the Construction of Gram-Positive and Gram-Negative Cell Walls
Have you ever been curious about the specific criteria that classify bacteria into Gram groups? Do they possess unique markers or small identifiers on their surfaces? Lets embark on this journey of discovery together!